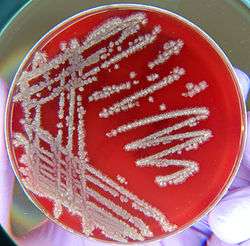

Bacillus licheniformis
| Bacillus licheniformis | |
|---|---|
| |
| Bacillus licheniformis colonies on a blood agar plate. | |
| Scientific classification | |
| Kingdom: | Bacteria |
| Phylum: | Firmicutes |
| Class: | Bacilli |
| Order: | Bacillales |
| Family: | Bacillaceae |
| Genus: | Bacillus |
| Species: | B. licheniformis |
| Binomial name | |
| Bacillus licheniformis | |
Bacillus licheniformis is a bacterium commonly found in the soil. It is found on bird feathers, especially chest and back plumage, and most often in ground-dwelling birds (like sparrows) and aquatic species (like ducks).
It is a gram-positive, mesophilic bacterium. Its optimal growth temperature is around 50 °C, though it can survive at much higher temperatures. The optimal temperature for enzyme secretion is 37 °C. It can exist in spore form to resist harsh environments, or in a vegetative state when conditions are good.
High capacity of secretion of the alkaline serine protease has made B. licheniformis one of the most important bacteria in industrial enzyme production.[1] Subtilisin Carlsberg secreted by B. licheniformis is used as a detergent protease. It is sold under the name Alcalase by Novozymes.[2] A small antisense RNA against Subtilisin Carlsberg named BLi_r0872 was discovered in an RNA-seq based study. It may have a putative impact on protease production and serve as target for strain improvement.[3]
Scientists are currently exploring its ability to degrade feathers for agricultural purposes. Feathers contain high amounts of non-digestible proteins, but researchers hope that, through fermentation with B. licheniformis, they can use waste feathers to produce cheap and nutritious feather meal to feed livestock.
Ecological research is also being done looking at the interaction between plumage colors and B. licheniformis activity, and the consequences thereof. Feather degrading bacteria may have played an important role in the evolution of molting, and patterns in feather coloration (Gloger's Rule).
Feather degradation
Bacillus licheniformis degrades feathers of parrots and other birds, especially white feathers. Red feathers with high levels of psittacofulvin are more resistant.[4]
Biological laundry detergent
Bacillus licheniformis is cultured in order to obtain protease for use in biological laundry detergent. The bacterium is well adapted to grow in alkaline conditions, so the protease it produces can withstand high pH levels, making it ideal for this use - the other components of detergents create an alkaline pH. The protease has a pH optimum of between 9 and 10 and is added to laundry detergents in order to digest, and hence remove, dirt made of proteins. This allows for much lower temperatures to be used, resulting in lower energy use and a reduced risk of shrinkage of garments or loss of colored dyes.
Dental applications
In 2012, scientists from Newcastle University studying Bacillus licheniformis as a possible agent to clean ships' hulls isolated an enzyme that has proven to be an unexpected tooth decay fighter as it has the ability to cut through plaque or a layer of bacteria.[5]
Nanotech applications
Bacillus licheniformis can be used in synthesis of gold nanocubes.[6] Researchers have synthesized gold nanoparticles with sizes between 10 and 100 nanometres. Gold nanoparticles are usually synthesized at high temperatures, in organic solvents and using toxic reagents. The bacteria produce them in much milder conditions.
Natural genetic transformation
B. licheniformis is naturally competent for genetic transformation.[7] Natural genetic transformation is a sexual process involving DNA transfer from one bacterium to another through the intervening medium, and the integration of the donor sequence into the recipient genome by homologous recombination.
References
- ↑ Schallmey, Marcus; Singh, Ajay; Ward, Owen P. (2004-01-01). "Developments in the use of Bacillus species for industrial production". Canadian Journal of Microbiology. 50 (1): 1–17. doi:10.1139/w03-076. ISSN 0008-4166. PMID 15052317.
- ↑ "UniProtKB".
- ↑ Wiegand, Sandra; Dietrich, Sascha; Hertel, Robert; Bongaerts, Johannes; Evers, Stefan; Volland, Sonja; Daniel, Rolf; Liesegang, Heiko (2013-01-01). "RNA-Seq of Bacillus licheniformis: active regulatory RNA features expressed within a productive fermentation". BMC genomics. 14: 667. doi:10.1186/1471-2164-14-667. ISSN 1471-2164. PMC 3871023
 . PMID 24079885.
. PMID 24079885. - ↑ Edward H. Burtt, Max R. Schroeder, Lauren A. Smith, Jenna E. Sroka, Kevin J. McGraw (2010): Colourful parrot feathers resist bacterial degradation, Biology Letters, The Royal Society, doi:10.1098/rsbl.2010.0716.
- ↑ Wilkinson, Tom (4 July 4, 2012). "Seaweed could fight tooth decay – scientists". Independent.ie. Check date values in:
|date=(help) - ↑ Kalishwaralal, Kalimuthu; Deepak, Venkataraman; Ram Kumar Pandian, Sureshbabu; Gurunathan, Sangiliyandi (1 November 2009). "Biological synthesis of gold nanocubes from Bacillus licheniformis". Bioresource Technology. 100 (21): 5356–5358. doi:10.1016/j.biortech.2009.05.051.
- ↑ Jakobs M, Hoffmann K, Grabke A, Neuber S, Liesegang H, Volland S, Meinhardt F (2014). "Unravelling the genetic basis for competence development of auxotrophic Bacillus licheniformis 9945A strains". Microbiology (Reading, Engl.). 160 (Pt 10): 2136–47. doi:10.1099/mic.0.079236-0. PMID 25009236.
External links
- Isolation, Identification, and Characterization of a Feather Degrading Bacteria, Williams et al., 1990
- Bacterial Degradation of Black and White Feathers, Goldstein et al., 2003
- Complete genome of Bacillus licheniformis ATCC14580 - publication
- Microbial nanotechnologists, August 1, 2009
- Bacillus licheniformis genome
- Type strain of Bacillus licheniformis at BacDive - the Bacterial Diversity Metadatabase